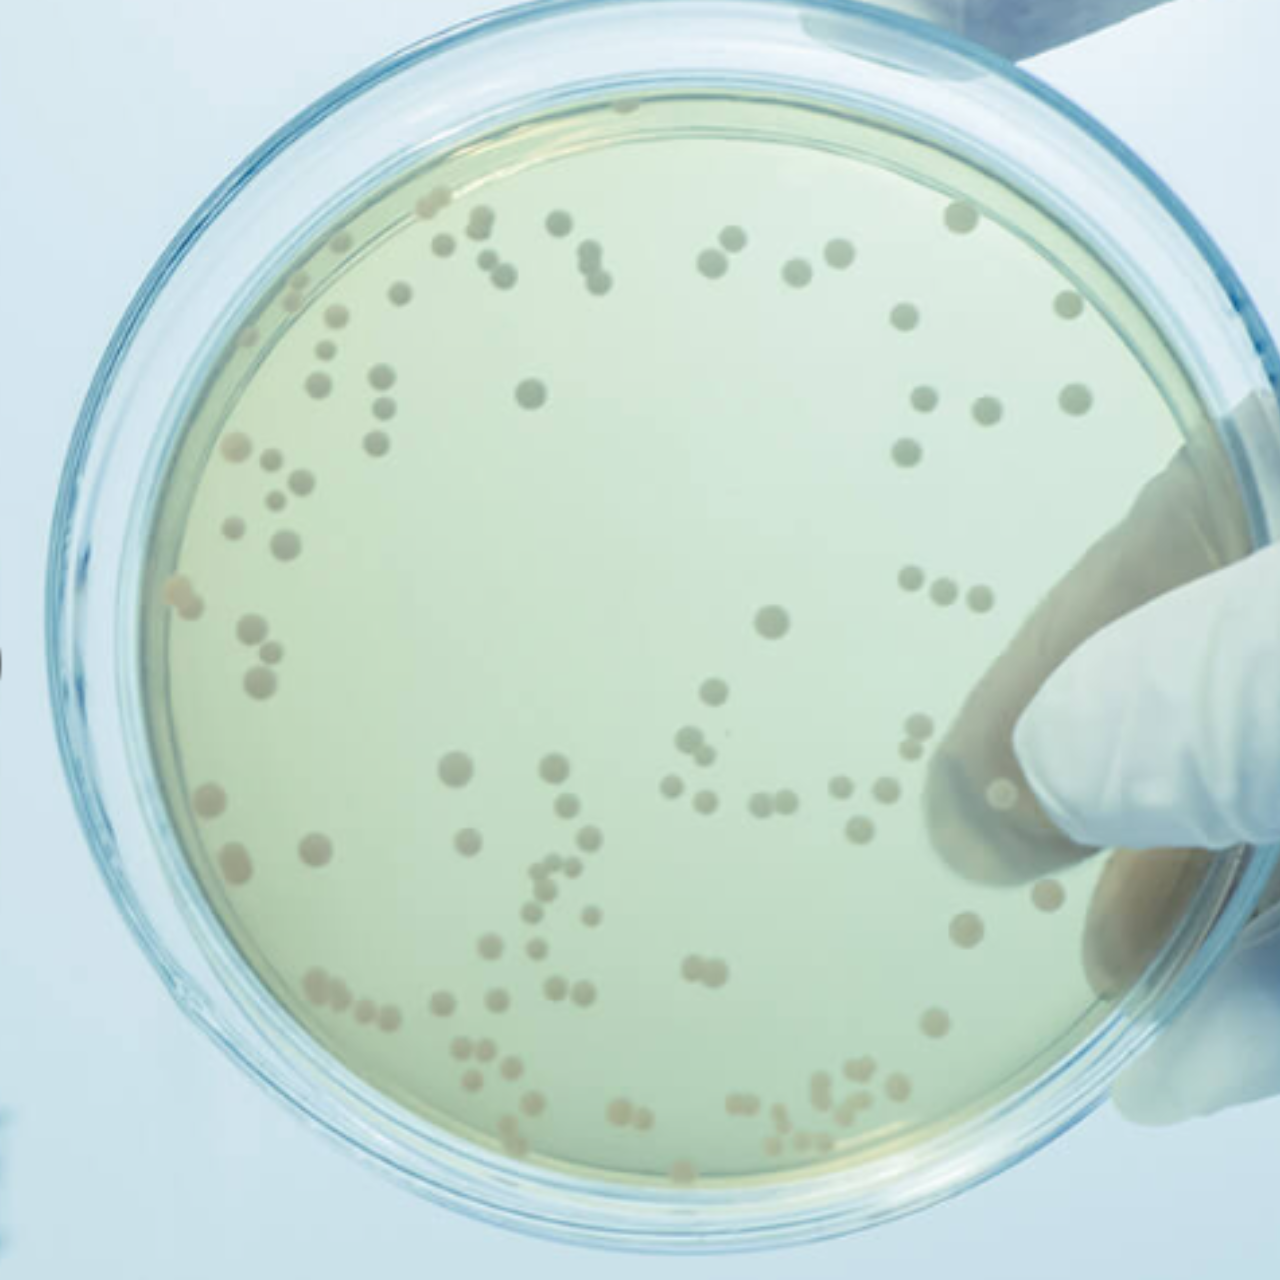
Plate R2A Agar

AQU@Sense MB
- Controllo completamente automatizzato durante il processo: integrazione perfetta nei sistemi di purificazione dell'acqua per un monitoraggio automatico in tempo reale.
- Monitoraggio dell'andamento: il rilevamento precoce di scostamenti o andamenti anomali nei sistemi di purificazione dell'acqua consente un intervento proattivo.
- Distribuzione rapida di acqua farmaceutica: consente ai sistemi di acqua purificata o per iniettabili la distribuzione entro 2-3 ore dopo la sanificazione.
- Strumento con validazione primaria: completamente validato secondo le farmacopee (USP e PhEur) e PDA TR33
- Tecnologia comprovata: utilizza la citometria a flusso con marcatura integrata, per rilevare in modo affidabile microrganismi vitali.
Il futuro del monitoraggio microbiologico: AQU@Sense MB
Ora è disponibile un controllo completamente automatizzato durante i processi di rilevazione e conteggio di microorganismi.
Mantieni il controllo dei sistemi di acqua purificata e iniettabile attraverso regolari misurazioni e il monitoraggio dell'andamento. Ottieni i risultati entro 20 minuti, agevolando rapidi processi decisionali e un tempestivo rilevamento dell'andamento. Uno strumento utile, completamente automatico per il monitoraggio microbiologico, ai fini dell'ottimizzazione della qualità del prodotto e dell'efficienza del processo.


Conta delle cellule vitali (ICC) anziché delle unità formanti colonie (CFU): una nuova misurazione
Il numero delle cellule vitali è, in comparazione con i metodi tradizionali, significativamente più alta rispetto a quella delle unità formanti colonia
Il confronto di diversi metodi per individuare microorganismi ha dimostrato che il numero delle cellule individuali è molto più alto rispetto ai risultati della conta dei microrganismi eterotrofi (HPC). I microscopi elettronici a scansione e a fluorescenza hanno dimostrato che una colonia sul rispettivo terreno è tipicamente originata da molte cellule individuali.Perfetta integrazione
Integrazione meccanica:
Punto di campionamento singolo
Punto multiplo con fino a 4 punti di campionamento
AQU@Sense MB può essere abbinato a un sistema di valvole che possono collegare fino a quattro punti di campionamento a uno strumento. Il controllo della sequenza di misurazione viene effettuato dall'unità di controllo del sistema acqua.
Modi di misurazione:
- Manuale: la misurazione può essere avviata manualmente con un intervallo minimo di campionamento di 30 minuti
- Automatico: è possibile programmare in AQU@Sense MB un intervallo di misurazione automatico tra 30 minuti e 6 ore
- Telecontrollato: la misurazione può essere attivata tramite segnali di input digitali con un intervallo minimo di campionamento di 30 minuti.
Trasferimento dati:
- Da 4 a 20 mA
- Modbus
Dettagli tecnici
| Dettagli tecnici | |
| Numero di articolo: | P06170006 |
| Dimensioni (L x P x H): | 350x270x373mm |
| Peso: | 14 kg |
| Tipo di protezione: | IP65 |
| Ambiente di esercizio: ambiente interno: | +5°C - +35°C, 10% - 90% UR |
| Principio di misurazione: | citometria a flusso con marcatura specifica del DNA.
segnale a rifrazione laterale e 2 a fluorescenza |
| Volume campione: | 90 µl |
| Campionamento: | online, misurazione singola offline oppure offline con gestione campioni per massimo 30 campioni |
| Tempo di analisi: | 30 minuti (tempo per i risultati: ~20 minuti) |
| Intervallo di misurazione: |
minimo 30 minuti (manuale, automatico o attivato con input digitale) |
| Sanitizzabile: |
ozono fino a 100 ppb/acqua calda fino a 85°C |
| Alimentazione elettrica: | 18 VDC, 1.4A, 20W |
| Uscita di comunicazione: |
2x4 ... 20mA uscite analogiche (configurabili a piacere) 4 uscite digitali Modbus TCP/IP |
| Ingresso di comunicazione: | 3 ingressi digitali (start, stop, interruzione misurazione) |
| Memoria dati: | scheda di memoria 32GB |
| Esportazione di dati: | USB 2.0, Ethernet |
| Documentazione elettronica: | 21 CFR Parte 11 documentazione elettronica conforme Audit Trail registro gestione utenti con 4 livelli utente |
| Conformità e certificazione: | certificazione CE, certificato di validazione della fabbrica |
| Volume standard di fornitura | Articolo | Numero di articolo P06170006 |
|
AQU@Sense MB Cartuccia Dispositivo di campionamento online Dispositivo di campionamento manuale Alimentazione elettrica/cavo |
Quali sono le differenze tra la conta delle piastre eterotrofe (HPC) e AQU@Sense MB?
| Conta dei microrganismi eterotrofi | AQU@Sense MB | |
| Tecnologia: | Basato sulla crescita, dipendente dal terreno di coltura | Analisi a fluorescenza dopo marcatura specifica del DNA |
| Campionamento: | Manuale | Automatico |
| Unità di misurazione: | Unità formanti colonia (CFU) | Conta delle cellule vitali (ICC) |
| Tempo per i risultati: | 3-7 giorni | 20 minuti (intervallo di misurazione 30 minuti) |
| Limite di detezione: | 1 colonia | 1 ICC |
| Campo: | 1-300 colonie per campione |
1-1 000 000 ICC per campione |
| Identificazione: |
Colonie |
Cellule individuali Diagramma a punti/impronta di una popolazione Interpretazione dei risultati a seconda degli eventi (monitoraggio dell'andamento) |
| Conteggio: | Conta visiva effettuata da persone | Automatico |
| Quantità campione: | 100 o 200ml | 90µl |
In che modo AQU@Sense MB distingue le cellule vitali e le cellule danneggiate/morte in un campione?
AQU@Sense MB utilizza due agenti coloranti specifici: SYBR Green I e ioduro di propidio. SYBR Green I penetra le membrane delle cellule vitali e si lega selettivamente al DNA della cellula. All'opposto, lo ioduro di propidio non è in grado di penetrare le membrane vive e si lega esclusivamente al DNA di cellule compromesse.
TPer determinare se solo SYBR Green I o se entrambi, SYBR Green I e ioduro di propidio, sono legati a una cellula: le cellule attraversano un vaso capillare molto sottile e illuminate con il laser, da cui si genera una luce rifratta e a fluorescenza e che può essere analizzata con un sistema di rilevamento specifico. SYBR Green I e ioduro di propidio emettono una fluorescenza su lunghezze d'onda distinte, il sistema può così differenziare tra cellule vitali e danneggiate.
Quali vantaggi offre AQU@Sense MB rispetto ad altri RMM?
- Tecnologia con validazione primaria da parte di scienziati indipendenti, garantendo così elevata credibilità e affidabilità
- Risultati chiari e certi, con la differenziazione tra cellule vitali e cellule danneggiate/frammenti
- Risultati riproducibili
- Elevata autonomia con la configurazione plug and play semplice, minimizzando gli interventi manuali
- Design industriale robusto
- Nessun contatto diretto dell'utente con sostanze chimiche o scarti
- Requisiti di manutenzione minimi
- Capacità di rilevamento avanzate, identificando le cellule individuali, anche all'interno di conglomerati o frammenti di biofilm, consentendo un monitoraggio dell'andamento esauriente.
Qual è la correlazione tra le due unità di misurazione CFU e ICC?
La conta delle cellule vitali (ICC) e le unità formanti colonie (CFU) non evidenziano una correlazione diretta. In primo luogo, è dovuto alla presenza delle cosiddette cellule vitali ma non coltivabili (VBNC), che non vengono rilevate nella conta dei batteri eterotrofi (HPC) ma più facilmente nella citometria a flusso. In secondo luogo, è dovuto alle differenze relative a tempi e fattori ambientali tra i due metodi. La citometria a flusso fornisce un'istantanea della presenza di cellule. Per questo motivo, le cellule che non prosperano alle condizioni HPC potrebbero essere ancora rilevabili tramite la citometria a flusso.
Di conseguenza, quando AQU@Sense MB viene impiegato come uno strumento nel controllo della qualità (QC), è necessaria una qualificazione delle prestazioni (PQ) presso il cliente per stabilire i parametri, inclusi i limiti di allerta e di azione.
Cosa sono gli organismi vitali ma non coltivabili (VBNC)? Hanno una grande importanza ai fini della sicurezza per il paziente?
Questi batteri VBNC restano vivi e metabolicamente attivi ma non sono in grado di crescere a condizioni di laboratorio standard. Studi recenti hanno dimostrato che lo stato VBNC è reversibile, ciò significa che questi microorganismi possono ritornare allo stato di moltiplicazione, rappresentando di fatto una potenziale carica microbiologica, e di riflesso, un rischio per la salute. La citometria a flusso aiuta a rilevare i microorganismi VBNC nell'acqua farmaceutica, perché utilizza metodi che non si basano sulla crescita.
È possibile identificare la specie con AQU@Sense MB?
Come si usa AQU@Sense MB nel monitoraggio quotidiano?
Esistono due campi di applicazione per le analisi di routine giornaliere. Controllo durante i processi (IPC) e controllo della qualità (QC).
Per l'IPC è possibile integrarlo nel sistema acqua come sistema di controllo online per il monitoraggio della carica microbiologica. Quando è in servizio alla massima capacità, AQU@Sense MB può eseguire continuamente fino a 48 misurazioni al giorno a lotti (intervallo di misurazione minimo: 30 minuti). L'intervallo di misurazione è regolabile a seconda delle esigenze e del servizio standard del sistema acqua. I vantaggi delle misurazioni frequenti sono evidenti:- rapido rilevamento anche di minimi cambiamenti, contrariamente ai metodi di conta dei batteri convenzionali. Questo sistema può essere utilizzato non solo per monitorare continuamente i livelli di carica microbiologica nel terreno di coltura, ma anche, ad es., per il rilascio del sistema acqua dopo la sanificazione o la manutenzione per il rilascio di acqua tecnica.
È possibile espletare le pratiche relative al controllo della qualità con AQU@Sense MB?
Sì, è possibile implementare gli assolvimenti relativi al controllo della qualità con AQU@Sense MB. Tuttavia, per l'integrazione nell'attuale processo di controllo della qualità, i clienti devono effettuare una qualifica delle prestazioni (PQ) per confermare la relativa idoneità per lo scopo previsto. Secondo la normativa vigente, AQU@Sense MB o altri metodi microbiologici rapidi (RMM) possono essere validati come metodo di controllo della qualità. Dal momento che AQU@Sense MB possiede già una validazione primaria, si semplifica la procedura della qualifica delle prestazioni.
È necessario eseguire una verifica di equivalenza utilizzando i parametri appropriati, seguita da un'analisi statistica visto che viene indicata una nuova unità di misurazione (conta delle cellule vitali, ICC) anziché le unità formanti colonia (CFU). Il risultato della verifica deve dimostrare che i risultati di AQU@Sense MB tengono conto di un risultato inequivocabile riguardo alla conformità agli standard evidenziati nella monografia, perfino nel confronto con il metodo HPC convenzionale.
AQU@Sense MB è riconosciuto dalle autorità (EMA, USP, FDA ecc.)?
AQU@Sense MB, insieme ad altri dispositivi RMM (stato novembre 2023), non è autorizzato in modo specifico per nome da alcun ente. Tuttavia, può essere validato e qualificato come un metodo di controllo della qualità, visto che la norma UE GMP, Allegato I, consiglia vivamente di integrare sistemi RMM.
Alla BWT stiamo lavorando per ottenere l'autorizzazione per il metodo applicato (citometria a flusso).
Download
Pubblicazioni scientifiche
Perfetta integrazione
Integrazione meccanica:
Punto di campionamento singolo
Punto multiplo con fino a 4 punti di campionamento
AQU@Sense MB può essere abbinato a un sistema di valvole che possono collegare fino a quattro punti di campionamento a uno strumento. Il controllo della sequenza di misurazione viene effettuato dall'unità di controllo del sistema acqua.
Modi di misurazione:
- Manuale: la misurazione può essere avviata manualmente con un intervallo minimo di campionamento di 30 minuti
- Automatico: è possibile programmare in AQU@Sense MB un intervallo di misurazione automatico tra 30 minuti e 6 ore
- Telecontrollato: la misurazione può essere attivata tramite segnali di input digitali con un intervallo minimo di campionamento di 30 minuti.
Trasferimento dati:
- Da 4 a 20 mA
- Modbus
Dettagli tecnici
| Dettagli tecnici | |
| Numero di articolo: | P06170006 |
| Dimensioni (L x P x H): | 350x270x373mm |
| Peso: | 14 kg |
| Tipo di protezione: | IP65 |
| Ambiente di esercizio: ambiente interno: | +5°C - +35°C, 10% - 90% UR |
| Principio di misurazione: | citometria a flusso con marcatura specifica del DNA.
segnale a rifrazione laterale e 2 a fluorescenza |
| Volume campione: | 90 µl |
| Campionamento: | online, misurazione singola offline oppure offline con gestione campioni per massimo 30 campioni |
| Tempo di analisi: | 30 minuti (tempo per i risultati: ~20 minuti) |
| Intervallo di misurazione: |
minimo 30 minuti (manuale, automatico o attivato con input digitale) |
| Sanitizzabile: |
ozono fino a 100 ppb/acqua calda fino a 85°C |
| Alimentazione elettrica: | 18 VDC, 1.4A, 20W |
| Uscita di comunicazione: |
2x4 ... 20mA uscite analogiche (configurabili a piacere) 4 uscite digitali Modbus TCP/IP |
| Ingresso di comunicazione: | 3 ingressi digitali (start, stop, interruzione misurazione) |
| Memoria dati: | scheda di memoria 32GB |
| Esportazione di dati: | USB 2.0, Ethernet |
| Documentazione elettronica: | 21 CFR Parte 11 documentazione elettronica conforme Audit Trail registro gestione utenti con 4 livelli utente |
| Conformità e certificazione: | certificazione CE, certificato di validazione della fabbrica |
| Volume standard di fornitura | Articolo | Numero di articolo P06170006 |
|
AQU@Sense MB Cartuccia Dispositivo di campionamento online Dispositivo di campionamento manuale Alimentazione elettrica/cavo |
Quali sono le differenze tra la conta delle piastre eterotrofe (HPC) e AQU@Sense MB?
| Conta dei microrganismi eterotrofi | AQU@Sense MB | |
| Tecnologia: | Basato sulla crescita, dipendente dal terreno di coltura | Analisi a fluorescenza dopo marcatura specifica del DNA |
| Campionamento: | Manuale | Automatico |
| Unità di misurazione: | Unità formanti colonia (CFU) | Conta delle cellule vitali (ICC) |
| Tempo per i risultati: | 3-7 giorni | 20 minuti (intervallo di misurazione 30 minuti) |
| Limite di detezione: | 1 colonia | 1 ICC |
| Campo: | 1-300 colonie per campione |
1-1 000 000 ICC per campione |
| Identificazione: |
Colonie |
Cellule individuali Diagramma a punti/impronta di una popolazione Interpretazione dei risultati a seconda degli eventi (monitoraggio dell'andamento) |
| Conteggio: | Conta visiva effettuata da persone | Automatico |
| Quantità campione: | 100 o 200ml | 90µl |
In che modo AQU@Sense MB distingue le cellule vitali e le cellule danneggiate/morte in un campione?
AQU@Sense MB utilizza due agenti coloranti specifici: SYBR Green I e ioduro di propidio. SYBR Green I penetra le membrane delle cellule vitali e si lega selettivamente al DNA della cellula. All'opposto, lo ioduro di propidio non è in grado di penetrare le membrane vive e si lega esclusivamente al DNA di cellule compromesse.
TPer determinare se solo SYBR Green I o se entrambi, SYBR Green I e ioduro di propidio, sono legati a una cellula: le cellule attraversano un vaso capillare molto sottile e illuminate con il laser, da cui si genera una luce rifratta e a fluorescenza e che può essere analizzata con un sistema di rilevamento specifico. SYBR Green I e ioduro di propidio emettono una fluorescenza su lunghezze d'onda distinte, il sistema può così differenziare tra cellule vitali e danneggiate.
Quali vantaggi offre AQU@Sense MB rispetto ad altri RMM?
- Tecnologia con validazione primaria da parte di scienziati indipendenti, garantendo così elevata credibilità e affidabilità
- Risultati chiari e certi, con la differenziazione tra cellule vitali e cellule danneggiate/frammenti
- Risultati riproducibili
- Elevata autonomia con la configurazione plug and play semplice, minimizzando gli interventi manuali
- Design industriale robusto
- Nessun contatto diretto dell'utente con sostanze chimiche o scarti
- Requisiti di manutenzione minimi
- Capacità di rilevamento avanzate, identificando le cellule individuali, anche all'interno di conglomerati o frammenti di biofilm, consentendo un monitoraggio dell'andamento esauriente.
Qual è la correlazione tra le due unità di misurazione CFU e ICC?
La conta delle cellule vitali (ICC) e le unità formanti colonie (CFU) non evidenziano una correlazione diretta. In primo luogo, è dovuto alla presenza delle cosiddette cellule vitali ma non coltivabili (VBNC), che non vengono rilevate nella conta dei batteri eterotrofi (HPC) ma più facilmente nella citometria a flusso. In secondo luogo, è dovuto alle differenze relative a tempi e fattori ambientali tra i due metodi. La citometria a flusso fornisce un'istantanea della presenza di cellule. Per questo motivo, le cellule che non prosperano alle condizioni HPC potrebbero essere ancora rilevabili tramite la citometria a flusso.
Di conseguenza, quando AQU@Sense MB viene impiegato come uno strumento nel controllo della qualità (QC), è necessaria una qualificazione delle prestazioni (PQ) presso il cliente per stabilire i parametri, inclusi i limiti di allerta e di azione.
Cosa sono gli organismi vitali ma non coltivabili (VBNC)? Hanno una grande importanza ai fini della sicurezza per il paziente?
Questi batteri VBNC restano vivi e metabolicamente attivi ma non sono in grado di crescere a condizioni di laboratorio standard. Studi recenti hanno dimostrato che lo stato VBNC è reversibile, ciò significa che questi microorganismi possono ritornare allo stato di moltiplicazione, rappresentando di fatto una potenziale carica microbiologica, e di riflesso, un rischio per la salute. La citometria a flusso aiuta a rilevare i microorganismi VBNC nell'acqua farmaceutica, perché utilizza metodi che non si basano sulla crescita.
È possibile identificare la specie con AQU@Sense MB?
Come si usa AQU@Sense MB nel monitoraggio quotidiano?
Esistono due campi di applicazione per le analisi di routine giornaliere. Controllo durante i processi (IPC) e controllo della qualità (QC).
Per l'IPC è possibile integrarlo nel sistema acqua come sistema di controllo online per il monitoraggio della carica microbiologica. Quando è in servizio alla massima capacità, AQU@Sense MB può eseguire continuamente fino a 48 misurazioni al giorno a lotti (intervallo di misurazione minimo: 30 minuti). L'intervallo di misurazione è regolabile a seconda delle esigenze e del servizio standard del sistema acqua. I vantaggi delle misurazioni frequenti sono evidenti:- rapido rilevamento anche di minimi cambiamenti, contrariamente ai metodi di conta dei batteri convenzionali. Questo sistema può essere utilizzato non solo per monitorare continuamente i livelli di carica microbiologica nel terreno di coltura, ma anche, ad es., per il rilascio del sistema acqua dopo la sanificazione o la manutenzione per il rilascio di acqua tecnica.
È possibile espletare le pratiche relative al controllo della qualità con AQU@Sense MB?
Sì, è possibile implementare gli assolvimenti relativi al controllo della qualità con AQU@Sense MB. Tuttavia, per l'integrazione nell'attuale processo di controllo della qualità, i clienti devono effettuare una qualifica delle prestazioni (PQ) per confermare la relativa idoneità per lo scopo previsto. Secondo la normativa vigente, AQU@Sense MB o altri metodi microbiologici rapidi (RMM) possono essere validati come metodo di controllo della qualità. Dal momento che AQU@Sense MB possiede già una validazione primaria, si semplifica la procedura della qualifica delle prestazioni.
È necessario eseguire una verifica di equivalenza utilizzando i parametri appropriati, seguita da un'analisi statistica visto che viene indicata una nuova unità di misurazione (conta delle cellule vitali, ICC) anziché le unità formanti colonia (CFU). Il risultato della verifica deve dimostrare che i risultati di AQU@Sense MB tengono conto di un risultato inequivocabile riguardo alla conformità agli standard evidenziati nella monografia, perfino nel confronto con il metodo HPC convenzionale.
AQU@Sense MB è riconosciuto dalle autorità (EMA, USP, FDA ecc.)?
AQU@Sense MB, insieme ad altri dispositivi RMM (stato novembre 2023), non è autorizzato in modo specifico per nome da alcun ente. Tuttavia, può essere validato e qualificato come un metodo di controllo della qualità, visto che la norma UE GMP, Allegato I, consiglia vivamente di integrare sistemi RMM.
Alla BWT stiamo lavorando per ottenere l'autorizzazione per il metodo applicato (citometria a flusso).
Download
Pubblicazioni scientifiche